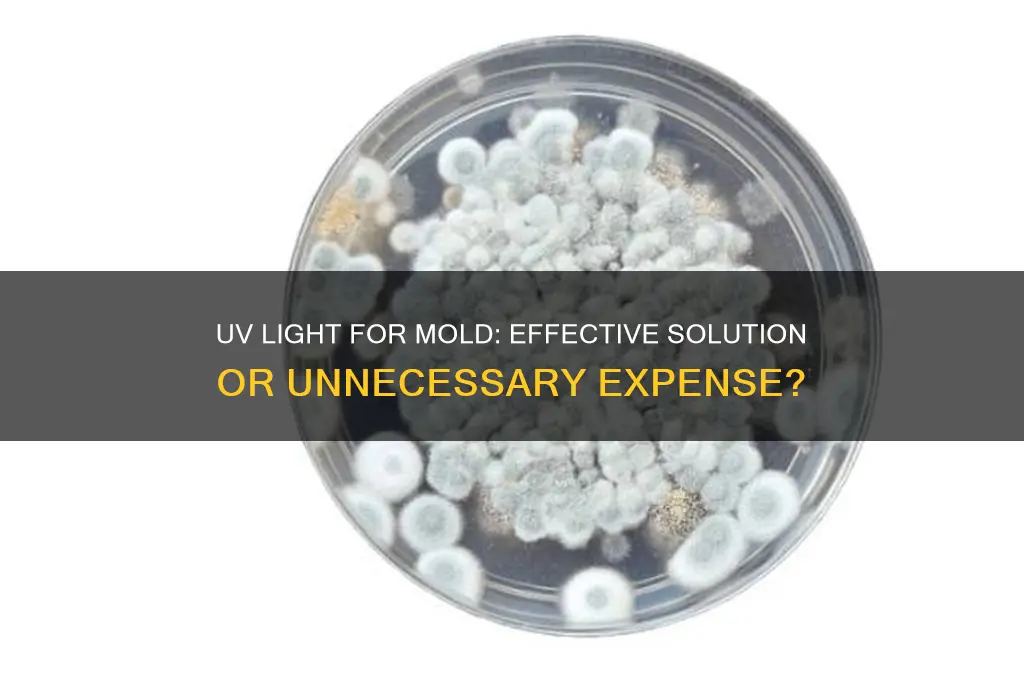
should i buy a uv light to kill mold spores

Considering whether to buy a UV light to kill mold spores involves weighing its effectiveness, safety, and practicality. UV-C light, a specific type of ultraviolet light, is known to destroy mold spores by damaging their DNA, making it a popular option for mold remediation. However, its efficacy depends on direct exposure, meaning it may not reach hidden or shadowed areas where mold often thrives. Additionally, UV lights can be harmful to humans and pets if not used properly, as prolonged exposure can cause skin and eye damage. Alternatives like HEPA air purifiers, dehumidifiers, and professional mold removal services may offer safer and more comprehensive solutions. Before investing in a UV light, it’s essential to assess the extent of the mold problem, ensure proper usage, and consider consulting experts for a tailored approach.
| Characteristics | Values |
|---|---|
| Effectiveness | UV-C light can kill mold spores on surfaces but is less effective in porous materials or hidden areas. |
| Type of UV Light | UV-C light (wavelength 200-280 nm) is required for mold spore inactivation. |
| Safety Concerns | UV-C light is harmful to humans and pets; requires unoccupied spaces during use. |
| Cost | Initial cost ranges from $50 to $500+ depending on device size and quality. |
| Maintenance | Bulbs need replacement every 6-12 months due to reduced efficacy over time. |
| Application Limitations | Works only on exposed surfaces; ineffective for mold within walls or fabrics. |
| Alternatives | HEPA air purifiers, dehumidifiers, and professional mold remediation are often more practical. |
| Energy Consumption | Varies by device; typically low to moderate energy usage. |
| Environmental Impact | Mercury-containing bulbs require proper disposal; energy-efficient models available. |
| Regulations | Must comply with safety standards (e.g., OSHA, EPA) for UV-C devices. |
| Long-Term Solution | Not a standalone solution; requires addressing moisture sources to prevent mold recurrence. |
| User Expertise | Requires careful installation and operation to avoid health risks. |
| Popularity | Increasing interest due to DIY mold control, but professional use is more common. |
What You'll Learn
- UV Light Effectiveness: Does UV light truly kill mold spores effectively and permanently
- Safety Concerns: Are UV lights safe for home use around humans and pets
- Cost vs. Benefit: Is the cost of UV lights justified for mold removal
- Alternative Methods: How do UV lights compare to other mold remediation techniques
- Maintenance Needs: What ongoing maintenance is required for UV light systems

UV Light Effectiveness: Does UV light truly kill mold spores effectively and permanently?
UV light, particularly in the UVC range (200-280 nanometers), is known for its germicidal properties, capable of damaging the DNA and RNA of microorganisms like bacteria and viruses. But when it comes to mold spores, the effectiveness of UV light is more nuanced. Mold spores are notoriously resilient, often surviving harsh conditions that would destroy other microbes. While UVC light can indeed inactivate mold spores by disrupting their cellular functions, the process requires precise conditions. For instance, the light must be of sufficient intensity (measured in millijoules per square centimeter) and exposure time must be adequate, typically ranging from 10 to 30 minutes depending on the setup. However, this effectiveness is often limited to surface-level mold, as UV light cannot penetrate materials like drywall or wood, leaving embedded spores untouched.
Consider the practical application of UV light in mold remediation. Portable UV lamps or HVAC-integrated systems are commonly marketed as solutions for mold control. However, these devices often fall short in real-world scenarios. For example, a UV lamp placed in a damp basement may reduce airborne spores but will do little to address mold colonies hidden behind walls or under flooring. Additionally, UV light’s effectiveness diminishes with distance; spores farther than 12 inches from the light source may receive insufficient exposure. This limitation underscores the importance of combining UV treatment with physical removal methods, such as scrubbing and HEPA vacuuming, for comprehensive mold eradication.
A comparative analysis of UV light versus other mold remediation methods reveals its strengths and weaknesses. Chemical treatments like bleach or hydrogen peroxide can penetrate surfaces and kill mold on contact, but they may leave behind residue and pose health risks. UV light, on the other hand, is chemical-free and environmentally friendly, making it appealing for sensitive environments like homes with children or pets. However, its inability to address root causes of mold—such as moisture intrusion—means it is not a standalone solution. For instance, a UV system installed in a bathroom with persistent leaks will only temporarily reduce spore counts until the underlying issue is resolved.
To maximize the effectiveness of UV light in mold control, follow these steps: First, identify and address the moisture source causing mold growth. Second, physically remove visible mold using appropriate protective gear and cleaning tools. Third, install a UVC light system in areas prone to mold, ensuring it is positioned to target surfaces and air pathways. Finally, monitor humidity levels and conduct regular inspections to catch mold early. While UV light can be a valuable tool in your mold-fighting arsenal, it is most effective when integrated into a broader strategy that includes prevention, physical removal, and environmental control.
In conclusion, UV light can kill mold spores effectively under controlled conditions, but it is not a permanent or comprehensive solution. Its surface-level impact and dependence on precise application make it a supplementary tool rather than a cure-all. For those considering purchasing a UV light for mold control, weigh its benefits against its limitations and pair it with proactive measures to manage moisture and physically remove mold. This balanced approach ensures that UV light contributes meaningfully to a healthier, mold-free environment.
Is Excadrill Immune to Stun Spore? Exploring Pokémon Abilities
You may want to see also

Safety Concerns: Are UV lights safe for home use around humans and pets?
UV-C light, the type effective against mold spores, is a double-edged sword. While its germicidal properties are undeniable, its safety profile demands careful consideration, especially in homes shared with humans and pets. The core issue lies in its wavelength: UV-C radiation (100-280 nanometers) is highly energetic, capable of damaging DNA and RNA in microorganisms, but also in living cells of humans and animals. This raises critical questions about exposure risks and necessary precautions.
Direct Exposure Risks:
Prolonged or intense exposure to UV-C light can cause skin irritation, resembling a sunburn, and eye damage, including photokeratitis (a painful inflammation of the cornea). The severity depends on exposure duration and intensity. For instance, a 1000-watt UV-C lamp operating for 15 minutes can deliver a harmful dose at a distance of 2 meters. Pets, particularly cats and dogs with lighter skin and fur, are even more susceptible due to their thinner epidermis and potential for closer proximity to the light source.
Indirect Exposure Concerns:
Even if humans and pets are not directly exposed, residual ozone production from some UV-C lamps poses a respiratory hazard. Ozone, a byproduct of UV-C interaction with oxygen, can irritate lungs and exacerbate respiratory conditions like asthma. This is particularly concerning for children, the elderly, and individuals with pre-existing respiratory issues.
Mitigating Risks:
To safely utilize UV-C lights for mold remediation, strict protocols are essential. Firstly, never occupy the treated area during operation. Ensure complete evacuation of humans and pets, and seal off the space if possible. Secondly, choose ozone-free UV-C lamps to eliminate this additional hazard. Thirdly, limit exposure time to the minimum effective duration, typically 15-30 minutes depending on the lamp's intensity and the mold infestation severity. Finally, ventilate the area thoroughly after treatment to disperse any residual ozone and allow safe re-entry.
Practical Considerations:
For targeted mold treatment in small areas, handheld UV-C wands can be effective, but require meticulous attention to avoid direct exposure. For larger spaces, consider professional-grade UV-C systems with built-in safety features like motion sensors and automatic shut-off mechanisms. Remember, UV-C light is a powerful tool, but its use demands respect for its potential dangers. Always prioritize safety by following manufacturer instructions, adhering to exposure guidelines, and consulting professionals when in doubt.
Toxoplasmosis Spores Lifespan: How Long Do They Survive in Environments?
You may want to see also

Cost vs. Benefit: Is the cost of UV lights justified for mold removal?
UV lights for mold removal can cost anywhere from $50 to $500, depending on the type, size, and brand. While this might seem like a significant investment, it’s essential to weigh this against the potential benefits. Mold spores can cause health issues such as allergies, respiratory problems, and even more severe conditions in immunocompromised individuals. If you’re dealing with a persistent mold problem, the long-term health benefits could justify the upfront cost. However, it’s crucial to understand that UV lights are not a standalone solution. They work best in conjunction with other mold remediation methods, such as improving ventilation and fixing moisture sources.
From an analytical perspective, the effectiveness of UV lights depends on proper usage. UV-C light, the type commonly used for mold, must be applied at a specific wavelength (around 254 nanometers) and for a sufficient duration (typically 1-2 hours per session) to kill mold spores effectively. Additionally, the light must have direct contact with the moldy surface, as UV rays cannot penetrate through dust, dirt, or other obstructions. This means that surfaces need to be cleaned before UV treatment, adding to the overall effort and time required. For small, contained areas, this might be manageable, but for larger spaces, the practicality diminishes.
A persuasive argument for UV lights is their eco-friendliness compared to chemical treatments. Unlike bleach or fungicides, UV lights leave no harmful residues and are safe for use around children and pets when used correctly. However, this benefit comes with a caveat: UV lights do not prevent mold from returning. Mold thrives in damp environments, so without addressing the root cause of moisture, the problem will persist. This raises the question of whether the cost of UV lights is justified if they don’t provide a long-term solution on their own.
Comparatively, other mold removal methods like HEPA vacuums, dehumidifiers, and professional remediation services offer different cost-benefit ratios. For instance, a dehumidifier, priced between $100 and $300, tackles the moisture issue directly, preventing mold growth at its source. Professional remediation, while expensive (ranging from $500 to $6,000), guarantees thorough removal and often includes preventive measures. UV lights, in contrast, are a middle-ground option—more affordable than professional services but less comprehensive. Their value lies in their ability to complement other methods, not replace them.
In conclusion, the cost of UV lights for mold removal is justified only if you’re prepared to use them as part of a multi-faceted approach. For small, accessible areas where mold is visible and surface-level, a UV light can be a cost-effective tool. However, for widespread or hidden mold, the investment may not yield significant returns without addressing underlying moisture issues. Before purchasing, assess the extent of your mold problem, consider the root cause, and evaluate whether UV lights align with your overall remediation strategy. Practical tips include ensuring the area is clean before treatment, using a timer to monitor exposure, and wearing protective gear to avoid UV exposure to skin and eyes.
Can Spore Run on Windows 8 via Steam? Compatibility Guide
You may want to see also

Alternative Methods: How do UV lights compare to other mold remediation techniques?
UV lights for mold remediation have gained attention, but they’re just one tool in a broader toolkit. While UV-C light can disrupt mold DNA, rendering spores inert, it’s not a standalone solution. Physical removal of mold-contaminated materials remains essential, as UV light cannot penetrate surfaces or eliminate the root cause of mold growth—moisture. For instance, if drywall is infested with mold, UV treatment alone won’t address the hyphae embedded within the material, necessitating replacement or professional cleaning.
Compared to traditional methods like HEPA vacuuming and chemical treatments, UV lights offer a chemical-free alternative, making them appealing for sensitive environments like homes with children or pets. However, their effectiveness is limited to exposed surfaces and requires prolonged exposure (typically 1–4 hours per area) to achieve significant spore reduction. In contrast, bleach or hydrogen peroxide solutions act faster but may damage surfaces and pose health risks if not used properly. For example, a 3% hydrogen peroxide solution can kill mold within 10 minutes but requires thorough ventilation to avoid respiratory irritation.
Another alternative, mold-inhibiting paints and sealants, provides long-term prevention by creating a barrier against moisture and spore growth. These products are ideal for high-humidity areas like bathrooms but don’t address existing mold. UV lights, while useful for air purification systems, lack this preventive aspect. For instance, a UV-C lamp installed in an HVAC system can neutralize airborne spores but won’t stop mold from regrowing in damp corners.
Steam cleaning emerges as a middle-ground solution, combining physical removal with heat-based sterilization. Using a commercial steamer at 175°F–212°F can kill mold on contact and penetrate porous materials better than UV light. However, it requires careful handling to avoid spreading spores or causing water damage. Unlike UV lights, which are hands-off but surface-limited, steam cleaning demands effort but delivers more comprehensive results.
Ultimately, the choice depends on the mold’s location, severity, and your priorities. UV lights excel in air purification and surface disinfection but fall short in remediation without complementary methods. For small, surface-level issues, a UV-C wand paired with HEPA vacuuming might suffice. For extensive infestations, professional removal followed by preventive measures like dehumidifiers and mold-resistant coatings is non-negotiable. Always address the moisture source first—UV lights can’t fix a leaky pipe or poor ventilation.
Run Spore Smoothly: Mastering Compatibility Mode for Seamless Gameplay
You may want to see also

Maintenance Needs: What ongoing maintenance is required for UV light systems?
UV light systems, while effective at neutralizing mold spores, are not set-it-and-forget-it solutions. Regular maintenance is crucial to ensure their continued efficacy. The primary task is cleaning the UV lamp itself. Dust, debris, and even dead mold particles can accumulate on the lamp’s surface, reducing its output intensity. A study by the *Journal of Environmental Health* found that a 10% reduction in UV intensity can decrease mold spore kill rates by up to 30%. Wipe the lamp with a soft, lint-free cloth and isopropyl alcohol every 3 months, or more frequently in dusty environments. Avoid abrasive materials that could scratch the lamp’s surface, as scratches can scatter UV light and diminish its effectiveness.
Beyond the lamp, the system’s housing and surrounding area require attention. Mold thrives in damp, dark conditions, so inspect the area around the UV system for leaks, condensation, or moisture buildup. Even a small water stain can indicate a problem. Additionally, ensure proper ventilation to prevent humidity from accumulating. For coil-mounted UV systems in HVAC units, clean the coils seasonally to remove dirt and debris that could block UV light. Neglecting this step can render the system ineffective, as UV light cannot penetrate thick layers of grime.
Lamp replacement is another critical aspect of maintenance. UV lamps degrade over time, losing intensity even if they still produce light. Most UV-C lamps (the type used for mold control) have a lifespan of 9,000 to 12,000 hours, roughly 1 to 1.5 years of continuous use. Replace the lamp annually, regardless of whether it appears to be functioning, to maintain optimal performance. Keep a log of replacement dates to avoid oversight. Using a lamp beyond its rated life not only reduces mold-killing efficiency but can also lead to system failure, as the ballast may overwork to compensate for the weakened lamp.
Finally, system alignment and positioning should be checked periodically. UV light must directly strike surfaces to kill mold spores, so ensure the system is correctly aimed and securely mounted. Vibration from HVAC systems or physical bumps can misalign the lamp over time. For duct-mounted systems, inspect the ductwork for leaks or damage that could allow mold spores to bypass the UV light. Proper alignment is particularly critical in high-humidity areas like bathrooms or basements, where mold growth is more likely.
In summary, maintaining a UV light system involves regular cleaning, environmental monitoring, timely lamp replacement, and system alignment checks. Skipping these steps can compromise the system’s ability to control mold, turning a potentially effective tool into a costly decoration. By investing 1–2 hours annually in maintenance, you can ensure the system operates at peak efficiency, providing long-term protection against mold spores.
Does Black Mold Have a Smell? Uncovering the Truth About Spores
You may want to see also
Frequently asked questions
UV lights can be effective at killing mold spores on surfaces, but they are not a standalone solution. They work best in conjunction with proper ventilation, moisture control, and physical removal of mold. UV lights are most effective in HVAC systems or enclosed spaces where mold is present but not accessible for manual cleaning.
UV-C lights, which are commonly used to kill mold spores, can be harmful to humans and pets if exposed directly. Prolonged exposure can cause skin and eye damage. It’s best to use UV lights in unoccupied spaces or with automatic shut-off features to ensure safety.
UV lights can kill mold spores on surfaces they directly expose, but they cannot penetrate porous materials or reach hidden areas where mold may thrive. To fully eliminate mold, you must address the source of moisture, clean affected areas, and use UV lights as a supplementary tool.
If you have persistent mold issues, especially in HVAC systems or damp areas, a UV light can be a worthwhile investment as part of a comprehensive mold prevention strategy. However, it’s not necessary for occasional mold problems or if proper moisture control and cleaning are already in place.

